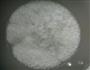
水晶晶月饼的做法图解2

| 水晶晶月饼热量分析 (可根据实际输入食材份量计算。数据仅供参考) | |||||
|---|---|---|---|---|---|
| 食材名称 | 食材份量 | 热量 | 标准度量(每100克) | 蛋白质 | 脂肪 |
| 西米 | 克 | 390千卡 | 195千卡 | 12.4克 | 2.2克 |
| 南瓜 | 克 | 59千卡 | 22千卡 | 0.7克 | 0.1克 |
| 紫薯 | 克 | 164千卡 | 74千卡 | 2.34克 | 0克 |
| 总量 | 692克 | 水晶晶月饼热量/卡路里613千卡 | |||

1/11. 准备好主料
2/11. 烧开水,放入西米

3/11. 蒸南瓜和紫薯,捣成泥

4/11. 用模具做成喜欢的形状

5/11. 西米煮至透明,煮时注意搅拌

6/11. 将西米冷却后放入模具

7/11. 喜欢甜的,可加入炼乳
8/11. 填入南瓜和紫薯
9/11. 再填上西米糊

10/11. 成品,也可蒙上保鲜膜吃冰品。

11/11. 可以品尝了,简单吧
西米的热量195千卡(每100克);有利含量:低胆固醇,低钠盐,低饱和脂肪酸,富含蛋白质;具有化痰、健脾、补肺等功效;
南瓜的热量22千卡(每100克);有利含量:低胆固醇,低钠盐,低饱和脂肪酸,富含钾;具有护肝、解毒杀虫、清热解毒等功效;可与火腿、猪肉、牛腩搭配;与梭子蟹、羊肉、苦瓜相克,同食可能会引起不适;
紫薯的热量74千卡(每100克);有利含量:低胆固醇,低钠盐,低饱和脂肪酸;具有减肥、健脾胃、补虚乏等功效;可与水芹菜、糙米、莲子搭配;与鸡胸肉、鸡胸脯肉、仔鸡相克,同食可能会引起不适;